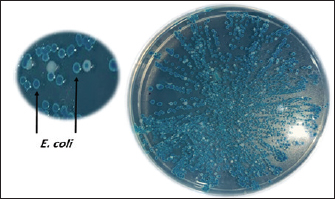

| Research Article | ||
Open Vet. J.. 2026; 16(1): 419-426 Open Veterinary Journal, (2026), Vol. 16(1): 419-426 Research Article Prevalence and phylogenetic analysis of avian pathogenic Escherichia coli strains from cases of colibacillosis infection in broiler chickens in different regions of Nineveh Governorate, IraqMeqdad Saleh Ahmed1, Dhyaa Mohammad Taher Jwher2*, Zanan Mohammed-Ameen Taha1, Farhad Buzo Mikaeel1 and Akeel Mohammad Shareef21Department of Pathology and Microbiology, College of Veterinary Medicine, University of Duhok, Duhok, Iraq 2Department of Veterinary Public Health, College of Veterinary Medicine, University of Mosul, Mosul, Iraq *Corresponding Author: Dhyaa Mohammad Taher Jwher. Department of Veterinary Public Health, College of Veterinary Medicine, University of Mosul, Mosul, Iraq. Email: diaataher [at] uomosul.edu.iq Submitted: 21/07/2025 Received: 15/11/2025 Accepted: 04/12/2025 Published: 31/01/2026 © 2025 Open Veterinary Journal
AbstractBackground: The primary causative agent of colibacillosis in broiler chickens is avian pathogenic Escherichia coli (APEC), leading to serious health problems and substantial economic losses in broiler production. Aim: This study aimed to investigate the prevalence and genetic diversity of APEC in broiler farms in the Nineveh Governorate, Iraq. Methods: From June 2024 to December 2024, 391 swab samples were collected from 76 broiler chicken farms and subjected to bacteriological and molecular analyses. Four tissue swabs (heart, air sacs, liver, and peritoneum) were pooled into a single sample for each bird. Escherichia coli was isolated using CHROMagar™ E. coli and confirmed through biochemical tests and polymerase chain reaction amplification of the 16S rRNA gene. A phylogenetic tree was constructed using the 16S rRNA-F and 16S rRNA-R primers for 10 local strains, each selected from a different region of Nineveh Governorate to ensure geographic representation. These strains were compared with reference strains from various countries. Results: The results revealed a high overall APEC prevalence of 78.26%, with regional rates ranging from 70.0% to 85.52%, with the highest prevalence observed in Rabia and Al-Hamdaniya. The phylogenetic analysis revealed marked genetic heterogeneity among the local strains, indicating that they are not all derived from a single source. Interestingly, some isolates clustered closely with strains previously reported from Turkey and Iran. This genetic relatedness indicates that E. coli could be introduced or exchanged through cross-border trade, bird migration, or other regional interactions in broiler chickens, thereby influencing the local epidemiology of the disease. Other strains formed distinct clades, indicating local evolution. Conclusion: These findings highlight the endemic presence and diverse genetic background of avian pathogenic E. coli in broiler chicken farms in Nineveh, underscoring the urgent need for enhanced biosecurity, surveillance, and control strategies. Keywords: Avian pathogenic Escherichia coli, 16S rRNA gene, Phylogenetic analysis, Genetic diversity, Broiler farms. IntroductionAvian pathogenic Escherichia coli (APEC) strains are responsible for a range of infections, including respiratory tract infections, septicemia, and cellulitis, making them a major concern in broiler chicken production (Hu et al., 2022). The pathogenicity of APEC is attributed to various virulence factors, such as adhesins, toxins, and iron-acquisition systems, which facilitate colonization and systemic infection (Kathayat et al., 2021). The phylogenetic classification of E. coli strains has become a vital tool for understanding their diversity, origin, and evolutionary relationships. The 16S rRNA gene is one of the most widely used molecular markers in microbiology, as it contains both highly conserved regions, which facilitate universal primer design and amplification across bacterial species, and variable regions, which provide the genetic diversity needed to distinguish between taxa. This unique combination makes it a powerful tool for phylogenetic studies, species identification, and evolutionary relationships among bacteria (Liu et al., 2012). This method helps identify distinct lineages and potential clonal spread within and between broiler chicken farms, which is critical for tracing infection sources and implementing effective control measures. Researchers can detect genetic similarities and divergences that may correlate with pathogenicity, antimicrobial resistance, or adaptation to specific host environments by comparing 16S rRNA gene sequences (Shabbir et al., 2023). Additionally, phylogenetic analysis provides insight into whether local strains are independently emerging or are introduced from external sources, such as trade or migratory birds, thereby informing biosecurity practices (De Carli et al., 2017; Jaseim, 2019). This is especially important in regions such as Nineveh, where biosecurity may vary among farms and surveillance data is limited, making molecular tools essential for guiding disease management strategies. However, regional and environmental factors, such as broiler chicken farming practices and biosecurity measures, may influence the distribution and evolution of APEC strains (Christensen et al., 2021). To the best of our knowledge, no study has investigated the prevalence and phylogenetic diversity of APEC in Nineveh. Moreover, limited information is available on whether Iraqi strains are locally evolving or are related to international isolates through cross-border transmission. Previous research in Iraq has primarily focused on the general isolation of E. coli, with little emphasis on the systematic phylogenetic analysis of broiler-associated APEC. Therefore, this study aimed to determine the prevalence of APEC in broiler farms across ten regions of Nineveh Governorate and analyze the genetic diversity and phylogenetic relationships of local APEC strains using 16S rRNA gene sequencing. This study will help establish the precise prevalence of APEC in broiler farms across Nineveh, assess regional variation in infection rates, and determine the genetic diversity of local strains. This study will also clarify how these strains relate phylogenetically to one another and to international reference strains, thereby informing the effectiveness of biosecurity measures at border entry points. Finally, whether the observed clustering patterns reflect local evolutionary processes or broader transmission dynamics will be determined. Materials and MethodsDescription of the study areaThe study was conducted in Nineveh Governorate, situated in northwestern Iraq, where the climate varies with the region’s diverse topography. Summer temperatures typically range from 40°C to 50°C, whereas winter temperatures fall between 0°C and 8°C (Al-Timimi and Al-Khudhairy, 2018). The region features a rich diversity of livestock, encompassing a wide variety of animal species. Many broiler chicken breeding fields are distributed in many of its districts (its districts and sub-districts), and they represent a portion of the meat production of local broiler chickens. Live chickens and hatching eggs are regularly imported from neighboring countries such as Turkey and Iran into Iraq. These imports help fill seasonal shortages in local production, meet rising demand for broiler chicks, and compensate for limitations in local hatchery capacity. However, these cross-border movements of poultry and poultry products may also introduce infectious agents, including APEC, influencing the regional epidemiology of poultry diseases. Sample collectionA total of 391 swab samples were collected from 76 broiler farms across 10 regions of Nineveh Governorate: Tal-Afar, Sinjar, Al-Ba’aj, Gogjali, Al-Hadhr, Rabia, Tel-Kaif, Al-Hamdaniya, Al-Sheikhan, and Al-Ayadhiya (Table 1) during the period from June 2024 to December 2024. Four tissue swabs (heart, air sacs, liver, and peritoneum) were pooled into a single sample for each bird. The number of samples obtained from each region varied with flock availability and farm density. Allowing for comparability across regions despite unequal sample sizes. The swab samples were obtained from either recently deceased chickens or live chickens following necropsy. Swabs were taken from the characteristic lesions (Fig. 1) by directly immersing them in the swabs. The samples were placed in sterile tubes containing BHIB (Himedia®, India), stored in cooled containers at 4°C–6°C, and promptly transported to the Scientific Research Laboratory at the College of Veterinary Medicine, University of Mosul, for bacteriological analysis.
Fig. 1. Chicken suspected of colibacillosis showing prominent fibrinous exudate covering the liver and heart (fibrinous perihepatitis and pericarditis), which are characteristic APEC infection-associated lesions. Table 1. Distribution of samples collected from broiler chicken farms in Nineveh Governorate.
Sample processing, Escherichia coli isolation, and identificationTo isolate E. coli, BHIB tubes were incubated for 18–24 hours at 37°C for 18–24 hours. After incubation, a suspension was streaked onto chromogenic agar (CHROMagar™ E. coli, CHROMagar, Paris, France). Typical colonies were subjected to biochemical confirmation by “Indole-production, methyl red, Voges-Proskauer, Simmons Citrate, Triple sugar iron, catalase, and oxidase,” according to Quinn et al. (2011). E. coli was confirmed molecularly through polymerase chain reaction (PCR) amplification of the 16s rRNA gene. Molecular investigationDNA extractionThe DNA of E. coli was extracted following the manufacturer’s protocol of the Presto™ Mini gDNA Bacteria Kit (Geneaid, Taiwan). DNA concentration was measured using a BioDrop® spectrophotometer (HBio, UK) and stored at −20°C for subsequent molecular confirmation. Conventional PCR amplification of the 16s rRNA geneBased on standard biochemical tests, the presumptively identified E. coli colonies were directly subjected to PCR amplification targeting the “16S rRNA” gene. The primer sequences were (F- AGAGTTTGATCMTGGCTCAG and R- CCGTCAATTCCTTTRAGTTT) to obtain a PCR product size of approximately 1,500 bp (Lateif et al., 2024). The amplifications were performed in a combined volume of approximately 25 μl, consisting of 12.5 μl of “hot start premix (Genedirex, Taiwan)”, 1 μl each of the reverse and forward primers (10 pmol), 4 μl of sample DNA (30–100 ng/μl), and the remaining portion was filled with nuclease-free water. The PCR amplification was carried out in a PCR system “9700 GeneAmp” (Applied Biosystems, USA)”, with initial denaturation step at 95°C for 6 minutes, followed by 35 cycles (95°C for 45 seconds, 1 minute at 55°C for 1 minute, 72°C for 1 minute, and 72°C for 1 minute), and a final cycle of 5 minutes at 72°C. The PCR amplicons were electrophoresed at 85 V for 40 minutes on a 1.5% agarose gel prepared with 1 × Tris-acetate-EDTA buffer (Lateif et al., 2024). The gel was stained using “RedSafe DNA staining solution (GeNetBio, Korea)” to visualize and confirm the presence of amplified products. DNA sequencingSequencing was performed on 10 samples using 16S rRNA-F and 16S rRNA-R primers. The samples were selected to represent different regions across the Nineveh Governorate, with one sample chosen from each region. Sanger sequencing was performed at the Macrogen Genome Center in Korea. Phylogenetic tree constructionThe 16S rRNA gene sequence analysis was used to compare the sequencing results using GenBank data and the NCBI’s basic local alignment search tool program (http://www.ncbi.nlm.nih.gov). A phylogenetic tree was constructed using the molecular evolutionary genetic analysis program using distance matrices and the maximum composite likelihood substitution method. To determine the node’s reproducibility for tree structure, bootstrap research employing 1,000 × data sets was conducted (Tamura et al., 2021). The phylogenetic tree analysis in this study was constructed using 18 strains (10 from this study and 8 from NCBI). Ethical approvalAll procedures performed in this study involving chicken samples were reviewed and approved by the Ethics Committee of the Institutional Animal Care and Use Committee at the College of Veterinary Medicine/University of Mosul, UM.VET.2024.120. Dated: 17/3/2024. ResultsPrevalence of pathogenic avian Escherichia coliA total of 391 swab samples were collected from 76 broiler farms across 10 regions in Nineveh Governorate, Iraq, and screened for APEC. Of these, 306 samples tested positive, yielding an overall prevalence of 78.26%. APEC was identified based on multiple criteria, including the presence of characteristic lesions on the liver and heart observed during necropsy (Fig. 1), the development of distinctive blue colonies on CHROMagar™ E. coli (Fig. 2), and the detection of the expected 1,500 bp PCR amplicon of the 16S rRNA gene (Fig. 3). Table 3 presents a detailed regional distribution of the results, including the number of farms sampled, total samples collected, number of APEC-positive samples, and corresponding positivity rates.
Fig. 2. Blue colonies of E. coli after growth on chromogenic agar.
Fig. 3. PCR amplification products of the 1500 bp 16S rRNA of E. coli isolates. Table 3. List of bacterial isolates of geographic origin and GenBank accession numbers.
Regionally, the prevalence rates ranged from 70.0% (14/20) to 85.52% (65/76). The highest APEC positivity was observed in Rabia at 85.52% (65/76), followed closely by Al-Hamdaniya at 85.18% (46/54). Gogjali recorded 80.85% (38/47), and Al-Ayadhiya showed 76.66% (23/30). Al-Ba’aj demonstrated a prevalence of 76.19% (32/42), while Tel-Kaif yielded 74.07% (20/27). Al-Sheikhan recorded 72.72% (16/22). Tal-Afar and Sinjar had nearly identical prevalence rates of 71.42% (25/35) and 71.05% (27/38), respectively. The lowest regional prevalence was found in Al-Hadhr at 70.0% (14/20) (Table 2). Table 2. Number and percentage of positive samples obtained from different regions.
Phylogenetic tree analysis and genetic analysisA total of 10 E. coli strains were successfully sequenced, each originating from broiler chicken farms with colibacillosis. The sequences were deposited in GenBank under the accession numbers LC844818.1–LC844827.1 (Table 3). A phylogenetic tree was constructed to assess the genetic relationships among 10 local E. coli strains isolated from different regions within Nineveh Governorate and to compare them with E. coli reference strains from Turkey, the United States, Brazil, Iran, Egypt, Iraq, Jordan, and the United Kingdom. The resulting tree reveals that the local 10 Nineveh isolates are distributed across multiple branches with considerable genetic diversity. Distribution of these strains across multiple branches rather than a single clonal cluster. However, some of them were closely clustered, specifically LC844821.1 and LC844822.1. Some local strains exhibited high similarity to international strains. For instance, LC844820.1 clustered closely with the Turkish isolate (OM319668.1). Additionally, LC844827.1 showed proximity to the Iranian strain (OK001867.1). In contrast, other local strains, such as LC844826.1 and LC844824.1, formed independent branches from foreign isolates. The Egyptian strain (LC764402.1) and the Iraqi isolate (OM442029.1) were placed on separate branches but still showed moderate association with certain local strains. Interestingly, the strains from the USA (NR_024570.1), Brazil (JX865453.1), and the UK (KR265355.1) were positioned on more distant clades from the majority of local isolates (Fig. 4).
Fig. 4. Distance matrices and the maximum composite likelihood substitution phylogenetic tree of 10 local broiler chicks derived from E. coli strains. Overall, the phylogenetic tree demonstrates both intraregional similarity among Iraqi E. coli strains and a clear genetic distinction from strains isolated in more distant geographical locations. DiscussionThis study aimed to investigate the prevalence, genetic diversity, and phylogenetic relationships of APEC strains in broiler farms across different regions of Nineveh Governorate, Iraq. By integrating bacteriological, molecular, and phylogenetic approaches, this study aimed to provide insights into the distribution patterns of APEC, assess potential sources and routes of transmission (including cross-border introductions vs. local evolution), and generate data that can inform biosecurity, surveillance, and control strategies for improving poultry health and production in the region. The high prevalence of APEC detected across broiler farms in the Nineveh region points to a widespread and persistent challenge to the health of broiler chickens in this area (Joseph et al., 2023). This elevated rate is consistent with findings from other low-to-middle-income regions, where APEC prevalence often reflects suboptimal farm conditions, limited veterinary oversight, and inadequate disease control strategies (Christensen et al., 2021). The consistently high infection rates observed in most regions suggest that APEC is endemic and may be reinforced by systemic factors affecting broiler chicken farming at both the local and regional levels (Jamali et al., 2024). According to Kathayat et al. (2021), Escherichia coli is classified as APEC when it is found outside the intestinal tract (i.e., as extraintestinal pathogenic E. coli), where it can cause both systemic and localized infections. These infections may affect multiple organs and systems in birds of various ages, leading to diseases such as colibacillosis, which result in considerable economic losses and negatively impact bird health. Samples were collected from sick and recently deceased birds during necropsy, as they showed lesions consistent with colibacillosis. The E. coli isolates obtained in our study were classified as avian pathogenic E. coli based on these criteria. One potential explanation for this widespread prevalence is the variation in environmental, biosecurity, and management practices among farms (Adebowale et al., 2022; Zaki et al., 2024). Regions such as Rabia and Al-Hamdaniya, which reported the highest positivity rates, may have favorable environmental or operational conditions for APEC survival and transmission. These could include overcrowding, poor litter management, inadequate ventilation, or insufficient cleaning and disinfection protocols (Waliaula et al., 2024). These areas may also have higher levels of farm interconnectivity, such as shared water sources, feed suppliers, or transportation networks, which facilitate pathogen spread (Al-Sabawi and Jwher, 2022). Conversely, the lowest observed prevalence in Al-Hadhr may reflect relatively better biosecurity practices or less intensive broiler production (Miro and Jwher, 2025). However, the infection rates remained above 70% even in regions with fewer farms and samples, such as Al-Sheikhan and Al-Hadhr, indicating that the pathogen is well established and possibly circulating through environmental reservoirs or through vertical and horizontal transmission pathways (Manges and Johnson, 2017; Oikarainen et al., 2019) that are not confined to specific localities. The uniformity of high prevalence across diverse regions indicates gaps in disease surveillance, prevention, and control programs. A lack of routine diagnostic testing, limited farmer awareness, and lack of vaccination strategies may be intensifying the problem (Grace et al., 2024). Regional differences in infrastructure, access to veterinary care, and farm worker training could contribute to the observed variability in infection rates (Aworh et al., 2019; Christensen et al., 2021). This study’s phylogenetic analysis provides valuable insights into the genetic diversity, phylogenetic relationships, and potential transmission dynamics of APEC strains isolated from different regions of Nineveh Governorate. These findings clarify the evolutionary and epidemiological context of APEC strains in Iraq and their connections to global lineages. The phylogenetic tree revealed considerable genetic diversity among the 10 local APEC isolates. The distribution of these strains across multiple branches, rather than a single clonal cluster, indicates that this bacterium in Nineveh is genetically heterogeneous. This diversity may reflect multiple sources of infection, independent evolutionary histories, or varied selective pressures across broiler chicken farms in the city (Mehat et al., 2021). However, the presence of distinct sub-clades, such as those formed by LC844819.1 with LC844823.1, and LC844821.1 with LC844822.1, suggests some degree of local clustering, possibly due to shared environmental conditions or localized transmission among close-proximity farms (Dupas et al., 2024). The comparison with international reference strains provided an important context for evaluating local isolates’ relatedness. Certain Nineveh strains displayed high genetic similarity to international strains, indicating shared evolutionary origins or recent dissemination events (Mageiros et al., 2021; Hammad et al., 2022). For example, LC844820.1 showed close phylogenetic proximity to a Turkish strain (OM319668.1), and LC844827.1 was genetically similar to an Iranian isolate (OK001867.1). These connections point to possible cross-border transmission, potentially facilitated by the movement of broiler chicken products, trade, or migratory birds common to these countries (Goka et al., 2024; Zhang et al., 2025). However, the frequent movement of broiler chicken products across borders carries a considerable risk of introducing and disseminating infectious agents. Among these, APEC is of particular concern because it can be transmitted through apparently healthy birds, contaminated eggs, or associated materials. Such introductions not only complicate local disease control efforts but also influence the broader regional epidemiology of poultry diseases by facilitating the circulation of diverse pathogenic strains, potentially including multidrug-resistant variants. In contrast, some local isolates, such as LC844826.1 and LC844824.1, occupied unique and independent branches, showing limited similarity to both local and international strains. These strains may represent distinct evolutionary lineages that have emerged locally, possibly through long-term adaptation to specific ecological or farm conditions in Nineveh (Mageiros et al., 2021). These findings are consistent with a scenario in which APEC strains in Nineveh are shaped by both endemic evolutionary processes and occasional introductions of foreign lineages. The presence of both closely related and genetically distinct strains within the same geographic area underscores the complexity of APEC epidemiology and the need for continuous surveillance to monitor strain evolution and prevent outbreaks. Beyond their economic impact on poultry farming, APEC strains also pose a significant public health concern under the One Health perspective. Many APEC virulence genes and resistance determinants overlap with those found in human-infected extraintestinal pathogenic E. coli, raising the possibility of zoonotic transmission through direct contact, contaminated food products, or environmental pathways (Kathayat et al., 2021). The spread of multidrug-resistant APEC strains increases the risk of transferring resistance genes to human pathogens, thereby complicating clinical treatment options. This interconnectedness between poultry health, human health, and environmental reservoirs highlights the need for integrated surveillance and control strategies (Hu et al., 2022). Therefore, addressing APEC infections is essential not only for improving poultry production and farm biosecurity but also for safeguarding public health by reducing the potential cross-species dissemination of virulent and resistant strains (Ahmed et al., 2025). These results have significant consequences for veterinarians, policymakers, and poultry farmers. Farmers should concentrate on enhancing farm-level biosecurity, sanitation, litter management, and ventilation to lessen APEC transmission. They should also minimize overcrowding and regulate farm connectivity. By conducting routine diagnostic tests, directing immunization programs, and offering disease prevention and management training, veterinarians can assist in such efforts. Policymakers should prioritize establishing surveillance systems, rules governing farm biosecurity requirements, and cross-border poultry trade monitoring to stop the entry and spread of foreign APEC strains. By incorporating these strategies, the negative effects of APEC infections on the region’s economy and public health can be lessened. ConclusionThis study highlights the high prevalence of avian pathogenic E. coli in broiler farms across the Nineveh Governorate, likely due to inadequate biosecurity, environmental conditions, and diverse management practices. Regional differences in infection rates are linked to farm-level factors such as hygiene, crowding, and interconnectivity. Phylogenetic analysis demonstrated considerable genetic diversity among local strains, with evidence of both localized clustering and genetic relatedness to international isolates, indicating a combination of local evolution and possible cross-border transmission. These findings emphasize the urgent need to strengthen farm-level biosecurity measures, establish effective surveillance programs, and explore the potential role of vaccination strategies as part of an integrated approach to APEC control in the region. LimitationsThis study has several limitations. Only 10 isolates were sequenced, which may not capture the full strain diversity. antimicrobial resistance and virulence profiling were not performed, and farm management data were unavailable, limiting insight into resistance, pathogenicity, and transmission factors. Advanced molecular methods, such as multilocus sequence typing or whole-genome sequencing, were also not used, reducing the resolution for distinguishing closely related strains. Future studies incorporating these aspects would provide a more comprehensive understanding of the epidemiology and pathogenicity of the isolates. AcknowledgmentWe would like to thank our colleagues who contributed to this study. Conflict of interestAccording to the authors of the manuscript, no conflicts of interest existed during the writing or data analysis. FundingThis study received no funding. Authors’ contributionsThe second and third researchers designed the experiment, and the other researchers participated in the work, analyzing the results, writing the manuscript, and including the financial costs. Data availabilityAll references are available, so data can be obtained from the web. ReferencesAdebowale, O., Makanjuola, M., Bankole, N., Olasoju, M., Alamu, A., Kperegbeyi, E., Oladejo, O., Fasanmi, O., Adeyemo, O. and Fasina, F.O. 2022. Multi-drug-resistant Escherichia coli, biosecurity and anti-microbial use in live bird markets, Abeokuta, Nigeria. Antibiotics 11(2), 253–261. Ahmed, Z. S., Hashad, M. E., Atef, Y., Badr, H., Elhariri, M. and Kadry, M. 2025. Public health threat of antimicrobial resistance and virulence genes in Escherichia coli from human-chicken transmission in Egypt. Sci. Rep. 15(1),1–9. Al-Sabawi, A.H. and Jwher, Dh.M. 2022. The relationship between antibiotics resistance and biofilm formation for Escherichia coli isolated from sheep in Nineveh province, Iraq. J. Appl. Vet. Sci. 7(4), 28–33. Al-Timimi, Y. K., and Al-Khudhairy. A.A. 2018. Spatial and temporal temperature trends on Iraq during 1980-2015. J Physics: Conference Series, 1003(1), 1–12. Aworh, M.K., Kwaga, J., Okolocha, E., Mba, N. and Thakur, S. 2019. Prevalence and risk factors for multi-drug-resistant Escherichia coli among poultry workers in the Federal Capital Territory, Abuja, Nigeria. PLos One. 14(11), 1–15. Christensen, H., Bachmeier, J. and Bisgaard, M. 2021. New strategies to prevent and control avian pathogenic Escherichia coli (APEC). Avian. Pathol. 50(5), 370–381. De Carli, S., Gräf, T., Kipper, D., Lehmann, F.K.M., Zanetti, N., Siqueira, F.M., Cibulski, S., Fonseca, A.S.K., Ikuta, N. and Lunge, V.R. 2017. Molecular and phylogenetic analyses of Salmonella Gallinarum trace the origin and diversification of recent outbreaks of fowl typhoid in poultry farms. Vet. Microbiol. 212(1), 80–86. Dupas, M.C., Pinotti, F., Joshi, C., Joshi, M., Thanapongtharm, W., Dhingra, M., Blake, D., Tomley, F., Gilbert, M. and Fournié, G. 2024. Spatial distribution of poultry farms using point pattern modeling: a method to address livestock environmental impacts and disease transmission risks. PLos Comput. Biol. 20(10), 1–22. Goka, P.D., Folitse, R.D., Tasiame, W., Amemor, E., Burimuah, V., Asare, D.A. and Emikpe, B.O. 2024. Assessing cross-border live poultry trade as a possible factor for infectious diseases spread between Aflao and Lomé. PAMJ-One. Health. 14(7), 2–16. Grace, D., Knight-Jones, T.J.D., Melaku, A., Alders, R. and Jemberu, W.T. 2024. The public health importance and management of infectious poultry diseases in smallholder systems in Africa. Foods 13(3), 411–421. Hammad, A.M., Gonzalez-Escalona, N., El Tahan, A., Abbas, N.H., Koenig, S.S.K., Allué-Guardia, A., Eppinger, M. and Hoffmann, M. 2022. Pathogenome comparison and global phylogeny of Escherichia coli ST1485 strains. Sci. Rep. 12(1), T1–13. Hu, J., Afayibo, D.J.A., Zhang, B., Zhu, H., Yao, L., Guo, W., Wang, X., Wang, Z., Wang, D., Peng, H. and Tian, M. 2022. Characteristics, pathogenic mechanism, zoonotic potential, drug resistance, and prevention of avian pathogenic Escherichia coli (APEC). Front. Microbiol. 13(1), 1–13. Jamali, H., Akrami, F., Bouakkaz, S. and Dozois, C.M. 2024. Prevalence of specific serogroups, antibiotic resistance and virulence factors of avian pathogenic Escherichia coli (APEC) isolated from clinical cases: a systematic review and meta-analysis. Microb. Pathog. 194(1), 106843–106854. Jaseim, N.S. 2019. Molecular and phylogenetic study of avian pathogenic Escherichia coli (APEC) isolated from broilers in Al-Diwaniyah Province, Iraq. Al-Qadisiyah. J. Vet. Med. Sci. 18(1), 57–62. Joseph, J., Zhang, L., Adhikari, P., Evans, J.D. and Ramachandran, R. 2023. Avian pathogenic Escherichia coli (APEC) in broiler breeders: an overview. Pathog 12(11), 1280–1289. Kathayat, D., Lokesh, D., Ranjit, S. and Rajashekara, G. 2021. Avian Pathogenic Escherichia coli (APEC): virulence and Pathogenesis Factors, Zoonotic Potential, and Control Strategies. Pathog 10(4), 467–473. Lateif, B.M., Ahmed, J.A. and Najem, H.A. 2024. Genotypic characterization of Escherichia coli isolated from chickens infected in Basrah, Iraq. Online. J. Anim. Feed. Res. 14(1), 29–39. Liu, W., Li, L., Khan, M.A. and Zhu, F. 2012. Popular molecular markers in bacteria. Mol. Genet. MicrobiolVirol. 27(3), 103–107. Mageiros, L., Méric, G., Bayliss, S.C., Pensar, J., Pascoe, B., Mourkas, E., Calland, J.K., Yahara, K., Murray, S., Wilkinson, T.S., Williams, L.K., Hitchings, M.D., Porter, J., Kemmett, K., Feil, E.J., Jolley, K.A., Williams, N.J., Corander, J. and Sheppard, S.K. 2021. Genome evolution and the emergence of pathogenicity in avian Escherichia coli. Nat. Commun. 12(1), 765–772. Manges, A.R. and Johnson, J.R. 2017. Reservoirs of extraintestinal pathogenic Escherichia coli. Urinary Tract Infections. Mol. Path. Clin. Manag. 3(5), 159–177. Mehat, J.W., Van Vliet, A.H.M. and La Ragione, R.M. 2021. The avian pathogenic Escherichia coli (APEC) pathotype is comprised of multiple distinct, independent genotypes. Avian. Pathol. 50(5), 402–416. Miro, R.F. and Jwher, D.H.M. 2025. The relationship between biosecurity measures and the level of Staphylococcus aureus contamination in poultry farms in Northern Iraq. J. Appl. Vet. Sci. 10(2), 47–56. Oikarainen, P.E., Pohjola, L.K., Pietola, E.S. and Heikinheimo, A. 2019. Direct vertical transmission of ESBL/pAmpC-producing Escherichia coli limited in poultry production pyramid. Vet. Micro. 231(1), 100–106. Quinn, P.J., Markey, B.K., Leonard, F.C., Hartigan, P., Fanning, S. and Fitzpatrick, E. 2011. Veterinary microbiology and microbial disease. 2nd ed. New York, USA: John Wiley-Blackwel. Shabbir, M.Z., Kariyawasam, S., Pierre, T.A., Dunn, P.A., Wallner-Pendleton, E.A. and Lu, H. 2023. Identification, 16S rRNA–based characterization, and antimicrobial profile of Gallibacterium isolates from broiler and layer chickens. J. Vet. Diagn. Invest. 35(1), 13–21. Tamura, K., Stecher, G. and Kumar, S. 2021. MEGA11: molecular Evolutionary Genetics Analysis Version 11. Mol. Biol. Evol. 38(7), 3022–3027. Waliaula, P.K., Kiarie, E.G. and Diarra, M.S. 2024. Predisposition factors and control strategies of avian pathogenic Escherichia coli in laying hens. Front. Vet. Sci. 11(1), 1–21. Zaki, M.S., Fahmy, H.A., Khedr, M.H., Goha, M.A. and Attia, A.S. 2024. Relationship between poultry biosecurity assessments and Escherichia coli prevalence in poultry farms. J. Adv. Vet. Res. 14(3), 362–367. Zhang, S., Yang, J. and Abbas, M. 2025. Threats across boundaries: the spread of Enterobacteriaceae bacteria with ESBL and its challenge to the ‘one health’ concept. Front. Microbiol. 13(1), 1–26. | ||
| How to Cite this Article |
| Pubmed Style Ahmed MS, Jwher DMT, Taha ZM, Mikaeel FB, Shareef AM. Prevalence and phylogenetic analysis of avian pathogenic Escherichia coli strains from cases of colibacillosis infection in broiler chickens in different regions of Nineveh Governorate, Iraq. Open Vet. J.. 2026; 16(1): 419-426. doi:10.5455/OVJ.2026.v16.i1.38 Web Style Ahmed MS, Jwher DMT, Taha ZM, Mikaeel FB, Shareef AM. Prevalence and phylogenetic analysis of avian pathogenic Escherichia coli strains from cases of colibacillosis infection in broiler chickens in different regions of Nineveh Governorate, Iraq. https://www.openveterinaryjournal.com/?mno=272262 [Access: June 22, 2026]. doi:10.5455/OVJ.2026.v16.i1.38 AMA (American Medical Association) Style Ahmed MS, Jwher DMT, Taha ZM, Mikaeel FB, Shareef AM. Prevalence and phylogenetic analysis of avian pathogenic Escherichia coli strains from cases of colibacillosis infection in broiler chickens in different regions of Nineveh Governorate, Iraq. Open Vet. J.. 2026; 16(1): 419-426. doi:10.5455/OVJ.2026.v16.i1.38 Vancouver/ICMJE Style Ahmed MS, Jwher DMT, Taha ZM, Mikaeel FB, Shareef AM. Prevalence and phylogenetic analysis of avian pathogenic Escherichia coli strains from cases of colibacillosis infection in broiler chickens in different regions of Nineveh Governorate, Iraq. Open Vet. J.. (2026), [cited June 22, 2026]; 16(1): 419-426. doi:10.5455/OVJ.2026.v16.i1.38 Harvard Style Ahmed, M. S., Jwher, . D. M. T., Taha, . Z. M., Mikaeel, . F. B. & Shareef, . A. M. (2026) Prevalence and phylogenetic analysis of avian pathogenic Escherichia coli strains from cases of colibacillosis infection in broiler chickens in different regions of Nineveh Governorate, Iraq. Open Vet. J., 16 (1), 419-426. doi:10.5455/OVJ.2026.v16.i1.38 Turabian Style Ahmed, Meqdad Saleh, Dhyaa Mohammad Taher Jwher, Zanan Mohammed-ameen Taha, Farhad Buzo Mikaeel, and Akeel Mohammad Shareef. 2026. Prevalence and phylogenetic analysis of avian pathogenic Escherichia coli strains from cases of colibacillosis infection in broiler chickens in different regions of Nineveh Governorate, Iraq. Open Veterinary Journal, 16 (1), 419-426. doi:10.5455/OVJ.2026.v16.i1.38 Chicago Style Ahmed, Meqdad Saleh, Dhyaa Mohammad Taher Jwher, Zanan Mohammed-ameen Taha, Farhad Buzo Mikaeel, and Akeel Mohammad Shareef. "Prevalence and phylogenetic analysis of avian pathogenic Escherichia coli strains from cases of colibacillosis infection in broiler chickens in different regions of Nineveh Governorate, Iraq." Open Veterinary Journal 16 (2026), 419-426. doi:10.5455/OVJ.2026.v16.i1.38 MLA (The Modern Language Association) Style Ahmed, Meqdad Saleh, Dhyaa Mohammad Taher Jwher, Zanan Mohammed-ameen Taha, Farhad Buzo Mikaeel, and Akeel Mohammad Shareef. "Prevalence and phylogenetic analysis of avian pathogenic Escherichia coli strains from cases of colibacillosis infection in broiler chickens in different regions of Nineveh Governorate, Iraq." Open Veterinary Journal 16.1 (2026), 419-426. Print. doi:10.5455/OVJ.2026.v16.i1.38 APA (American Psychological Association) Style Ahmed, M. S., Jwher, . D. M. T., Taha, . Z. M., Mikaeel, . F. B. & Shareef, . A. M. (2026) Prevalence and phylogenetic analysis of avian pathogenic Escherichia coli strains from cases of colibacillosis infection in broiler chickens in different regions of Nineveh Governorate, Iraq. Open Veterinary Journal, 16 (1), 419-426. doi:10.5455/OVJ.2026.v16.i1.38 |